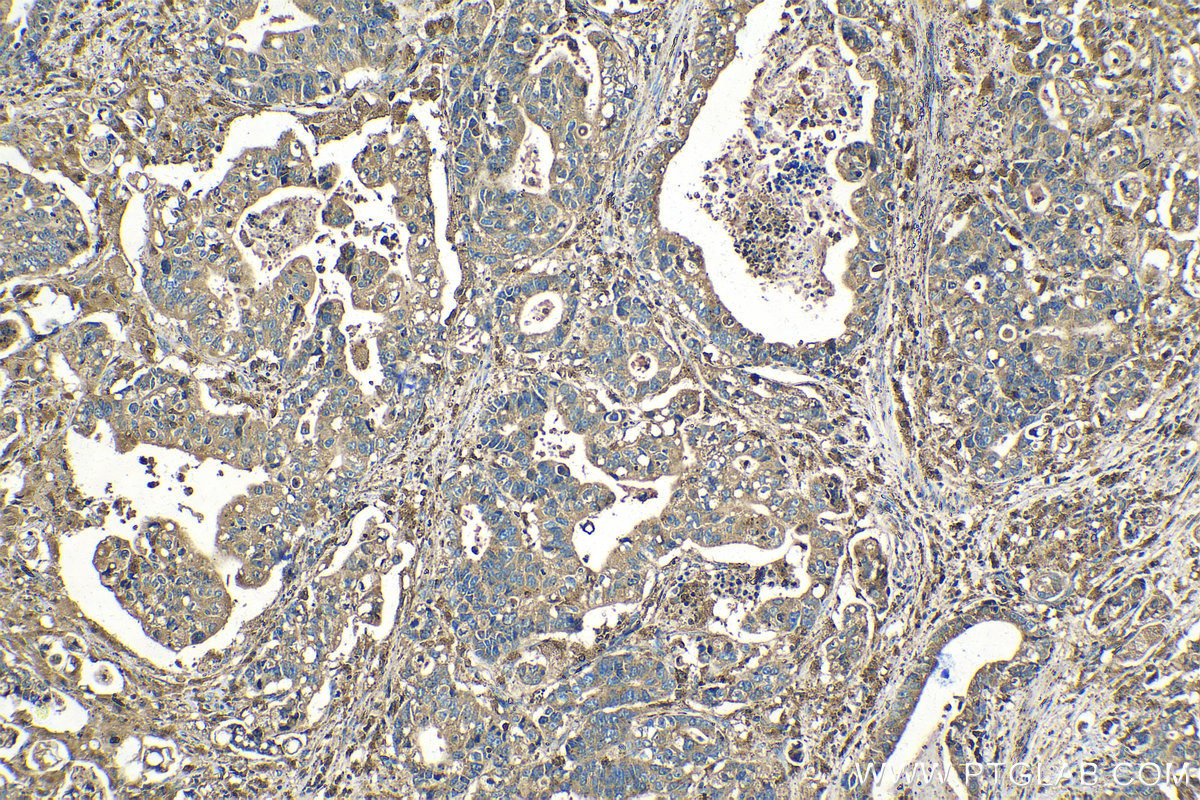

IHCeasy® PSAP Ready-To-Use IHC Kit
PSAP Ready-to-use reagent kit for IHC.
Reactivity
Human, Mouse, Rat
Sample Type
FFPE tissue
Cat no : KHC1407
Synonyms
A1 activator, Cerebroside sulfate activator, Co beta glucosidase, Component C, CSAct, Dispersin, GLBA, Glucosylceramidase activator, Proactivator polypeptide, prosaposin, Protein C, PSAP, SAP 1, SAP 2 Saposin D, SAP1
Validation Data Gallery
Product Information
KHC1407 is a ready-to-use IHC kit for staining of PSAP. The kit provides all reagents, from antigen retrieval to cover slip mounting, that require little to no diluting or handling prior to use. Simply apply the reagents to your sample slide according to the protocol and you're steps away from obtaining high-quality IHC data.
| Product name | IHCeasy PSAP Ready-To-Use IHC Kit |
| Sample type | FFPE tissue |
| Assay type | Immunohistochemistry |
| Primary antibody type | Rabbit Polyclonal |
| Secondary antibody type | Polymer-HRP-Goat anti-Rabbit |
| Reactivity | Human, Mouse, Rat |
Kit components
| Component | Size | Concentration |
|---|---|---|
| Antigen Retrieval Buffer | 100 mL | 50× |
| Washing Buffer | 100 mL ×2 | 20× |
| Blocking Buffer | 5 mL | RTU |
| Primary Antibody | 5 mL | RTU |
| Secondary Antibody | 5 mL | RTU |
| Chromogen Component A | 0.2 mL | RTU |
| Chromogen Component B | 4 mL | RTU |
| Signal Enhancer | 5 mL | RTU |
| Counter Staining Reagent | 5 mL | RTU |
| Mounting Media | 5 mL | RTU |
| Datasheet | 1 Copy | |
| Manual | 1 Copy |
Background Information
The PSAP gene encodes prosaposin, a precursor of four small nonenzymatic glycoproteins termed 'sphingolipid activator proteins' (SAPs) that assist in the lysosomal hydrolysis of sphingolipids. After proteolytic processing of the presaposin protein, these 4 released polypeptides are functional activators. Saposin A is encoded by residues 60 to 143 of PSAP, saposin B by 195 to 275, saposin C by 311 to 390, and saposin D by 405 to 487. Saposins A-D localize primarily to the lysosomal compartment where they facilitate the catabolism of glycosphingolipids with short oligosaccharide groups. Saposins A-D are required for the hydrolysis of certain sphingolipids by specific lysosomal hydrolases. Defects in PSAP are the cause of Gaucher disease, Tay-Sachs disease, and metachromatic leukodystrophy.
Properties
| Storage Instructions | All the reagents are stored at 2-8°C. The kit is stable for 6 months from the date of receipt. |
| Synonyms | A1 activator, Cerebroside sulfate activator, Co beta glucosidase, Component C, CSAct, Dispersin, GLBA, Glucosylceramidase activator, Proactivator polypeptide, prosaposin, Protein C, PSAP, SAP 1, SAP 2 Saposin D, SAP1 |